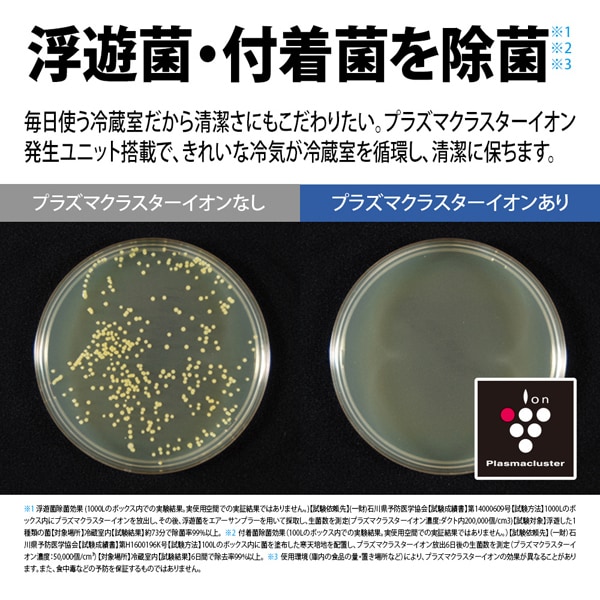

在庫あり 冷蔵庫 【設置込】 シャープ SHARP 502L 幅68.5cm フレンチドア(観音開き) 6ドア アッシュシルバー SJ-X502P-S ぎおん
166,000円(税込)
0ポイント(1%)
商品説明






■ SHARP(シャープ) ■
定格内容積:502L・幅68.5cm
たっぷり余裕の収納力。大容量冷凍室メガフリーザー170L
◆ 主な特長 ◆
●大容量冷凍室メガフリーザー170L
たっぷり入るから、まとめ買いも快適。充実の鮮度長持ち機能で、肉・魚・野菜も手作り総菜も、フレッシュな味をしっかりキープします。
●おいそぎ冷凍
おいしさを逃さないようすばやく冷凍します。
●新鮮冷凍
通常冷凍よりさらに低温で保存。また、霜取り運転前やドア開閉後に急冷し、温度上昇を防ぎます。霜つきを抑え、食品の鮮度を守ります。
●節電25
「節電25」モードを設定すると、冷蔵庫の使用状況を自動で判断し、各ご家庭の生活パターンに合わせて、かしこく省エネ運転。
●センターピラーレス
「センターピラー※」を必要としない独自構造で、電気のムダを抑えます。(ネイチャーテクノロジーホタテ貝ドアパーツ(ホタテ貝の凹凸形状)採用。)
※左右のドアの隙間を埋める柱。冷気もれ・霜付きを抑えるために、ヒーターを内蔵し、電力を消費します。
●浮遊菌・付着菌を除菌
毎日使う冷蔵室だから清潔さにもこだわりたい。プラズマクラスターイオン発生ユニット搭載で、きれいな冷気が冷蔵室を循環し、清潔に保ちます。
●棚全段取りはずし清掃
チルド上の棚まで全て取りはずしができるので、今まで掃除ができなかったところまで簡単にお掃除可能に。
●大きい氷でひと味違う晩酌に 大小切替製氷
通常サイズと2.3倍※1の大きさの大サイズの2種類を用途に合わせて選んでいただけます。
早く作りたいときはおいそぎ製氷モードも搭載。ミネラルウォーターも使えます。
※1 大サイズと標準サイズの比較。※2ミネラル成分の多い水を使った場合、氷に白い部分が多くなるなど、透明度が変わります。
●ユーティリティルーム
チルドルーム手前の「ユーティリティルーム」は、カレールーやスパイスなどのニオイの強い食材や、迷子になりやすい小物を入れておくのに便利です。

◆ 主な仕様 ◆
定格内容積:502L
各室容量
冷蔵室:259L [198L うちチルドルーム 18L]
製氷室:21L [6L]
冷凍室(上段):20L [11L]
野菜室:73L [49L]
冷凍室(下段):129L [86L]
※[ ]内の数字は食品収納スペースの目安
外形寸法(約):幅685×奥行699×高さ1,833mm
壁ぎわ設置した場合の壁からのスペース:20mm以上
最小必要設置スペース :幅695mm×奥行704mm×高さ1,883mm
質量(約):88.0kg
簡易商品仕様
シリーズ名:-
ブランド名:SHARP|シャープ
メーカー型番:SJ-X502P-S
代表カラー:シルバー
ドアの開き方:両開き(フレンチ)
定格内容積:502L
本体奥行:699mm
本体横幅:685mm
本体高さ:1833mm
独立製氷室:有
ドア数:6
冷凍室位置:下
年間電気代:7857円
脱臭機能:有
省エネ性マーク(緑):省エネ性マーク(緑)
カラー:アッシュシルバー
急速製氷:有
急速冷凍:有
ブランド名(カナ):シャープ
発売年月日(テキスト):2025年3月
配送サービス:設置対応可
定格内容積:502L・幅68.5cm たっぷり余裕の収納力。大容量冷凍室メガフリーザー170L 定格内容積:502L 各室容量 冷蔵室:259L [198L うちチルドルーム 18L] 製氷室:21L [6L] 冷凍室(上段):20L [11L] 野菜室:73L [49L] 冷凍室(下段):129L [86L] ※[ ]内の数字は食品収納スペースの目安 外形寸法(約):幅685×奥行699×高さ1,833mm 壁ぎわ設置した場合の壁からのスペース:20mm以上 最小必要設置スペース :幅695mm×奥行704mm×高さ1,883mm 質量(約):88.0kg ※記載は商品仕様の一部です。仕様説明不足等の理由での返品はできません。特に適合等は必ずご確認ください。
レビュー
商品の評価:



 -点(0件)
-点(0件)











